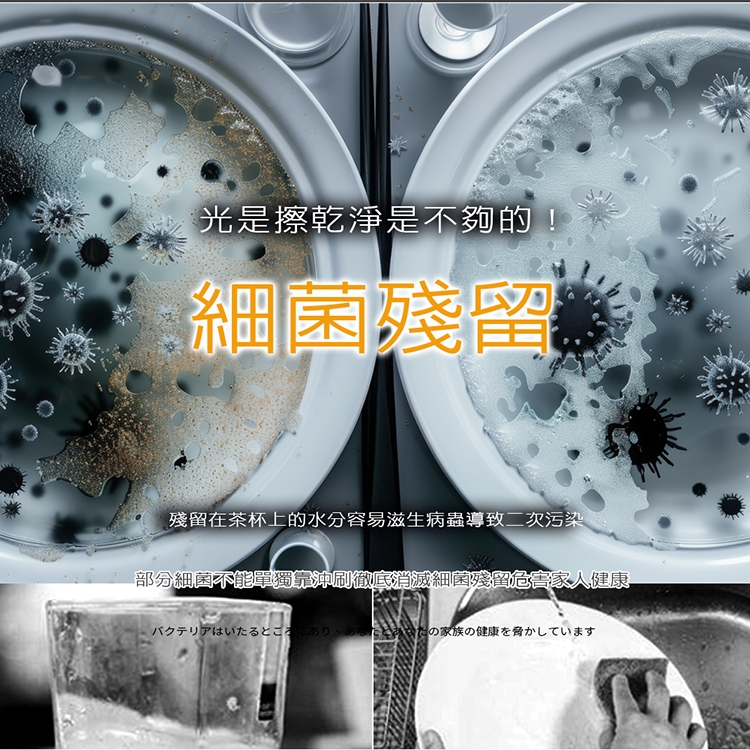

商品詳細介紹
【YAMASHITA 台灣山下】75L三層全不鏽鋼紫外線烘碗機(YS-7531D)保固一年到府收送
全不鏽鋼雙層內外殼更耐用
紫外線(殺菌跟烘乾)可獨立使用
75公升容量+三層碗盤架設計,小家庭最剛好
高效紫外線殺菌燈管,殺菌消毒效果強
面板「全自動/烘乾/殺菌 時間」選擇設定
內部採不鏽鋼材質,不生鏽,乾淨衛生的結構
防蟑門蓋設計,防蟑密封膠條,安全、衛生、耐高溫
安全強化玻璃門有效隔 離紫外線,並加貼防爆膠膜
開門自動熄滅殺菌燈,避免誤傷眼睛,安全無虞
門未關好,會自動發出嗶嗶聲提醒音訊
榮獲MIT微笑標章,品質保證
保固一年免費到府收送。(燈管、啟動器、消耗品不在此限)
贈不鏽鋼筷盒x1
商品屬於超大材積,大部分貨運都不收
宜蘭、花蓮、台東、屏東縣及部分偏遠地區,偏鄉山區
學校,公家機關,營區,醫院,地下室,工業區
賣場,百貨公司,碼頭,物流倉庫等等諸多地方
只要是貨運規劃的偏鄉將無法配送
會有專人告知無法配送,請多加留意訊息的部分
宅配無送上樓及夜間配送,如需送上樓,請自行跟司機協調上樓費用
下單前請先確認好家中放置的尺寸及開門方向,避免後續退貨造成彼此的困擾,謝謝

體驗說明
不可體驗
使用方法說明
插電即可使用
注意事項
商品到貨享十天猶豫期之權益(注意!猶豫期非試用期),依法辦理退貨商品必須是全新狀態且包裝完整(包含主機、附件、內外包裝、隨機文件、贈品等)。如商品一經拆封或使用致商品價值受損(例僅得以福利品出售),將向消費者就商品一部或全部價值減損收取適當之費用(回復原狀、整新費),否則將影響退貨的權限。請先確認商品正確、外觀可接受,再行開機/使用,以免影響您的權利